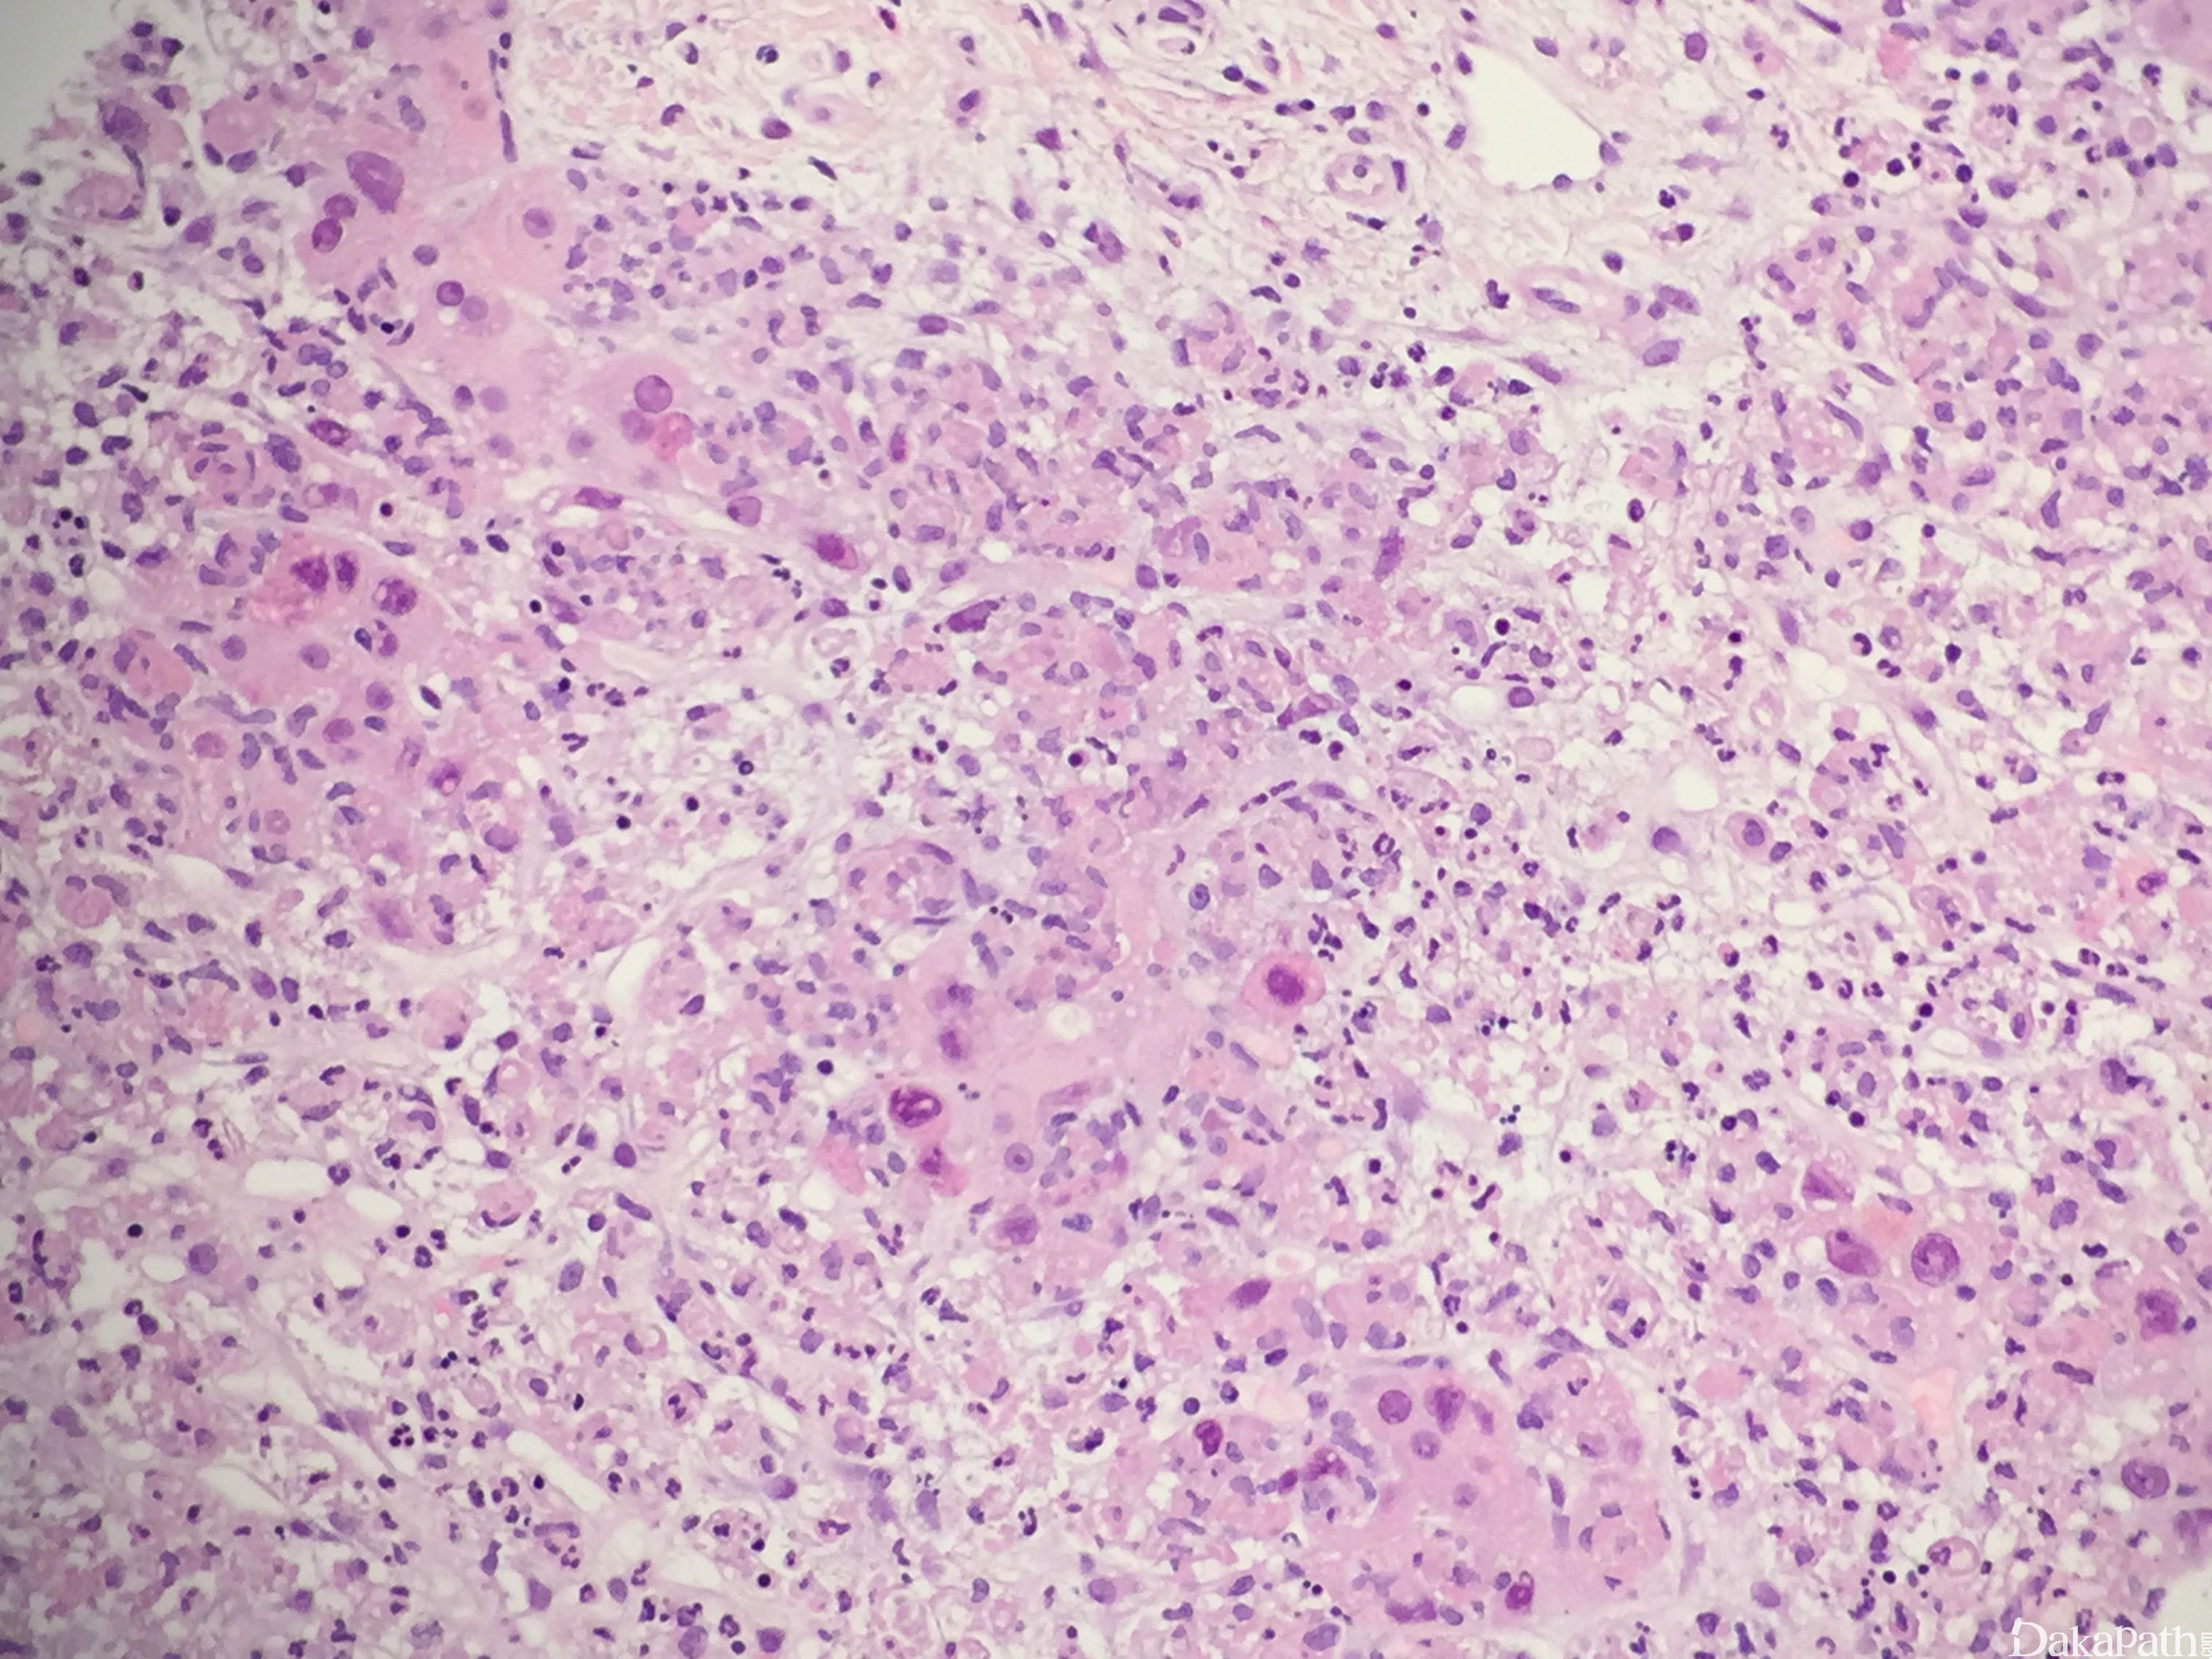

腺病毒
Adenovirus
概述:
腺病毒引起的肝炎
诊断要点:
临床上若发生在免疫功能正常的个体,则表现自限性疾病,可见呼吸道感染、结膜炎、出血性膀胱炎及胃肠炎。若发生在免疫功能低下的患者,可见肝炎、胰腺炎、肺炎、肾炎、脑炎或播散性疾病。暴发性肝炎常发生在免疫功能低下者或移植患者,可见高烧、黄疸及血清转氨酶明显升高。
实验室检测可通过聚合酶链反应进行病毒 DNA 检测、直接病毒抗原检测及病毒分离培养。
大体上可见肝肿大伴点状坏死灶。
组织上可见小或大的肝细胞凝固性坏死灶,坏死灶周围无或极轻微炎症反应。可见轻度非特异性小叶及汇管区可见炎细胞(淋巴细胞、中性粒细胞及嗜酸性粒细胞组成)浸润。可见小的形成不良的肉芽肿及微脓肿。感染的肝细胞可见核内病毒包涵体伴特征性模糊不清的核外观及染色质边集,常见于坏死灶的周围。感染的肝细胞无巨大或多核改变。少数感染的胆管系统的胆管上皮可见病毒包涵体,引起坏死性胆管炎及胆管缺失。
鉴别诊断:
单纯疱疹病毒性肝炎 感染的肝细胞可见轻度增大及多核,坏死区域可显示出血性改变,免疫组织化学染色有助于诊断。
水痘-带状疱疹病毒性肝炎 组织上与单纯疱疹病毒肝炎不易鉴别,存在典型皮损病变,免疫组织化学染色及聚合酶链反应有助于诊断。
巨细胞病毒性肝炎 大的嗜酸性核病毒包涵体周围显示透明空晕,胞浆病毒包涵体可见,常缺乏大的凝固性坏死灶,免疫组织化学染色有助于诊断。
药物诱导性肝炎 可显示更多的胆汁淤积及或脂肪变性,无病毒包涵体。
组织胞浆菌病 →